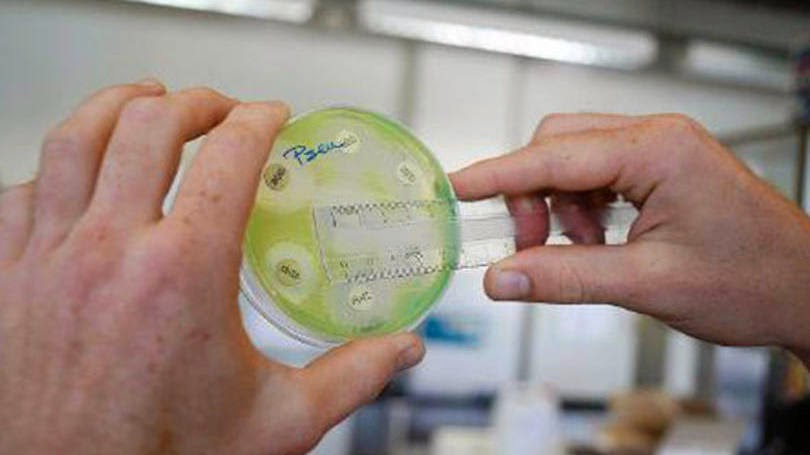

Coleta de bactérias: pelo menos sete bactérias diferentes responsáveis por doenças como pneumonia, diarreia ou infecções sanguíneas começam a ganhar resistência
Jamil Chade, do Estadão Conteúdo
Genebra - A resistência a antibióticos se transformou em uma "ameaça global" e doenças que eram curadas com relativa facilidade até há pouco tempo podem voltar a matar cerca de 10 milhões de pessoas até 2050.
O alerta faz parte de um plano que será apresentado pela Organização Mundial da Saúde (OMS) neste mês, na esperança de combater a resistência.
Os dados apontam para um cenário alarmante: pelo menos sete bactérias diferentes responsáveis por doenças como pneumonia, diarreia ou infecções sanguíneas começam a ganhar resistência.
Pelo menos dois produtos usados até hoje já não funcionam em metade da população, entre eles o antibiótico contra infecções urinárias causadas pela bactéria E. Coli.
Em 2013, a OMS calcula que 480 mil novos casos de tuberculose foram detectados por conta da resistência aos remédios, em mais de cem países. No caso da malária, a entidade considera a resistência como uma "preocupação urgente de saúde pública", diante do impacto em regiões inteiras.
Para a OMS, antibióticos se transformaram no pilar do desenvolvimento da medicina no século 20. Mas chegou o momento de agir para não perder o que o mundo atingiu. Numa era "pós-antibiótico", a realidade é que muitos morreriam de doenças que já foram controladas.
Para a indústria farmacêutica mundial, o crescimento da resistência microbiana pode ter repercussões até no PIB mundial, com uma queda entre 2% a 3,5%.
Na Federação Internacional das Indústrias Farmacêuticas, que reúne as maiores multinacionais do setor, as doenças causadas por bactérias, cada vez mais resistentes aos antibióticos disponíveis no mercado, aparecem como prioridade. Mas o grupo insiste para a necessidade de novos investimentos em medicamentos.
A OMS, em seu relatório publicado nesta semana sobre o mesmo assunto, também alerta para a falta de novos medicamentos. Segundo ela, nenhuma nova classe principal de antibióticos foi desenvolvida desde 1987. E não há resposta imediata.
Além da demora para desenvolver um novo medicamento - cerca de 10 a 20 anos-, a indústria farmacêutica vê seu retorno financeiro restrito a um prazo considerado extremamente longo, o que desestimula o investimento.
Planos nacionais
Por isso, a OMS insiste que apenas desenvolver novos remédios não será suficiente. A entidade vai recomendar que planos nacionais sejam desenvolvidos sobretudo em países emergentes. Mas a Federação das Indústrias Farmacêuticas diz que não há tecnologia nesses países.
Já para Fernando Bellisimo, professor da Faculdade de Medicina de Ribeirão Preto, o problema é mais uma questão de hábitos.
"No Brasil, existe o costume de acreditar que o médico mais eficiente é aquele que prescreve remédios. Infelizmente, pessoas continuam acreditando que antibióticos combatem doenças virais (o que não é verdade)", disse.
Bellissimo defende foco na prevenção e no combate à proliferação das bactérias resistentes. "É preciso maior atenção à higiene dentro dos hospitais."